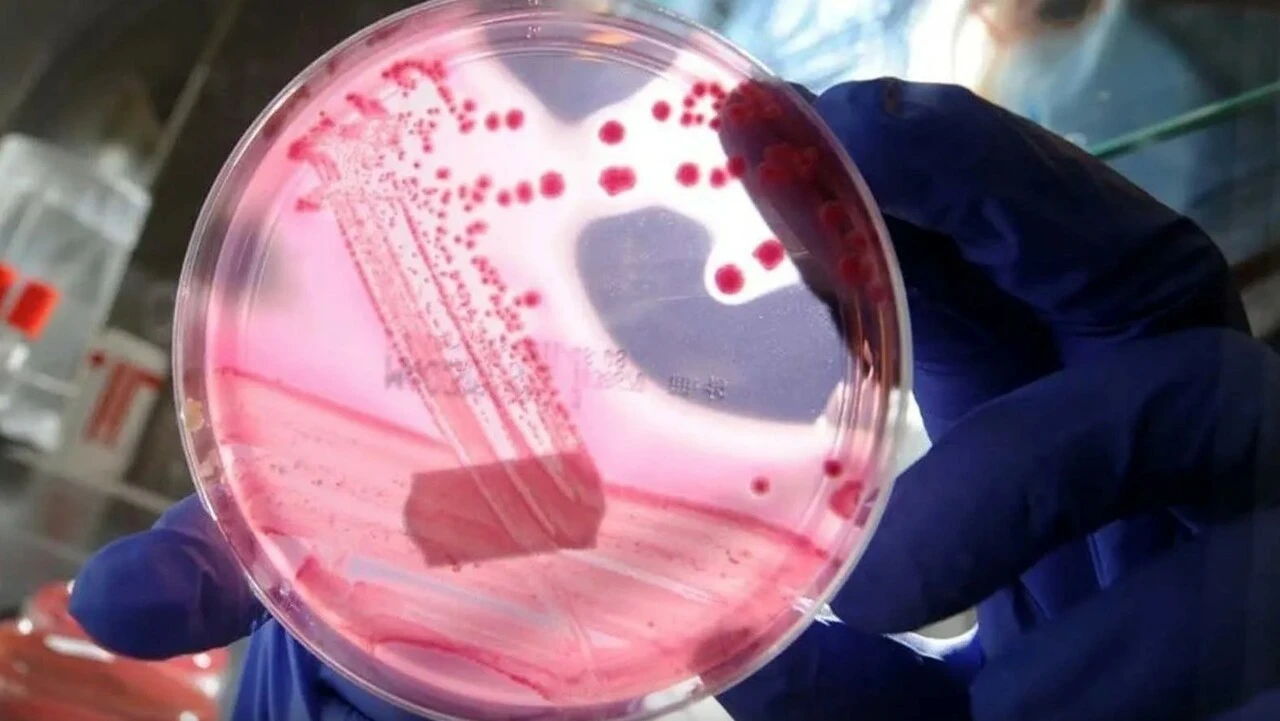
Küresel ısınma, 50 bin yıllık 'ölümü' ortaya çıkardı: Dünya yeni bir salgın tehlikesiyle karşı karşıya

Kategoriler
UYGULAMALAR
İstanbul
İnsanoğlu, uzun yıllardır buzulların altına hapsolmuş ve küresel ısınmayla birlikte yeniden ortaya çıkma ihtimali olan bir vürüs tehdidiyle karşı karşıya... Fransa'da Aix-Marseille Üniversitesi'nde gören yapan bilim insanları, 'zombi virüs' olarak adlandırılan Methuselah mikroplarınının buzulların erimesiyle tekrar ortaya çıktığını açıkladı. Bilim insanları, son bulgularla birlikte kutuplardaki incelemeleri daha yakından takip etmeye karar verdiklerini duyurdular.
Virüsün yeni bir pandemiye neden olup olmayacağına dair analizlerin devam ettiğini aktaran Aix-Marseille Üniversitesi'nden genetik uzmanı Jean-Michel Claverie, "Yayılabilecek bir salgına çok az dikkat edilmişti ve bence bu bir ihmaldir. Orada insanları enfekte etme ve yeni bir hastalık salgını başlatma potansiyeline sahip virüsler var" ifadelerini kullandı.

The Guardian'da yer alan habere göre; Rotterdam'daki Erasmus Tıp Merkezi'nden virolog Marion Koopmans da bu görüşü desteklediğini aktardı. Donmuş toprakta hangi virüslerin yattığını bilmediklerini ama bir salgını tetikleyebileceğini belirten Koopmans, "Örneğin eski bir çocuk felci türünü- bir virüsün bulunması gerçek bir risk. Böyle bir şeyin olabileceğini varsaymak zorundayız" değerlendirmesinde bulundu.

Geçen yıl yapılan bir diğer araştırmada ise Sibirya'daki yedi farklı bölgeden toplanan mikrop ve virüslerin kültürlenmiş hücreleri enfekte edebildiğini gözler önüne sermişti. Kullanılan virüs örneklerinden birinin yaklaşık 50 bin yaşında olduğu belirtildi.
Claverie önderliğindeki bilim insanları 2014 yılında bölgede inceleme yapmış ve bu mikropların binlerce yıldır donmuş toprakta gömülü olmasına rağmen halen tek hücreli organizmaları enfekte edebildiklerini keşfetmişti.

Bu virüslerin soğuk, karanlık ve oksijensiz donmuş topraklarda bulunduğuna fakat iklim değişikliğiyle birlikte bunların ortaya çıkabileceğine dikkat çeken uzmanlar bir diğer risk unsurunu da ele aldı.
En acil riski oluşturan şeyin doğrudan donmuş toprakların erimesi olmadığını belirtilen açıklamada; "Tehlike başka bir küresel ısınma etkisinden kaynaklanıyor: Kutup deniz buzunun ortadan kalkması. Bu da Sibirya'da gemicilik, trafik ve endüstriyel gelişimin artmasına olanak sağlıyor. Büyük madencilik operasyonları planlanıyor ve petrol ve cevher çıkarmak için derin donmuş toprakta büyük delikler açılacak" ifadelerine yer verildi.